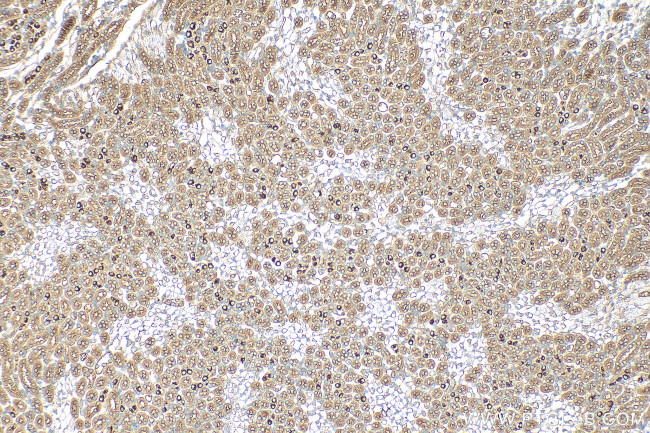
SUSD2 Antibody in Immunohistochemistry (Paraffin) (IHC (P))

Search
Proteintech
SUSD2 Polyclonal Antibody
{{$productOrderCtrl.translations['antibody.pdp.commerceCard.promotion.promotions']}}
{{$productOrderCtrl.translations['antibody.pdp.commerceCard.promotion.viewpromo']}}
{{$productOrderCtrl.translations['antibody.pdp.commerceCard.promotion.promocode']}}: {{promo.promoCode}} {{promo.promoTitle}} {{promo.promoDescription}}. {{$productOrderCtrl.translations['antibody.pdp.commerceCard.promotion.learnmore']}}
产品信息
30711-1-AP
种属反应
宿主/亚型
分类
类型
抗原
偶联物
形式
浓度
规格
纯化类型
保存液
内含物
保存条件
运输条件
产品详细信息
Sequence of this protein is as follows: MDLKGMFLSV AAGDRVSIML ASGAGLEVSV QGPFLSVSVL LPEKFLTHTH GLLGTLNNDP TDDFTLHSGR VLPPGTSPQE LFLFGANWTV HNASSLLTYD SWFLVHNFLY QPKHDPTFEP LFPSETTLNP SLAQEAAKLC GDDHFCNFDV AATGSLSTGT ATRVAHQLHQ RRMQSLQPVV S*
靶标信息
May be a cytokine receptor for C10ORF99. May be a tumor suppressor; together with C10ORF99 has a growth inhibitory effect on colon cancer cells which includes G1 cell cycle arrest (PubMed:25351403). May play a role in breast tumorigenesis (PubMed:23131994).
仅用于科研。不用于诊断过程。未经明确授权不得转售。
篇参考文献 (0)
生物信息学
蛋白别名: Sushi domain (SCR repeat) containing; Sushi domain-containing protein 2; testicular tissue protein Li 190; unnamed protein product
基因别名: 1200011D11Rik; BK65A6.2; SUSD2; W5C5
UniProt ID: (Human) Q9UGT4, (Mouse) Q9DBX3
Entrez Gene ID: (Human) 56241, (Mouse) 71733, (Rat) 294335